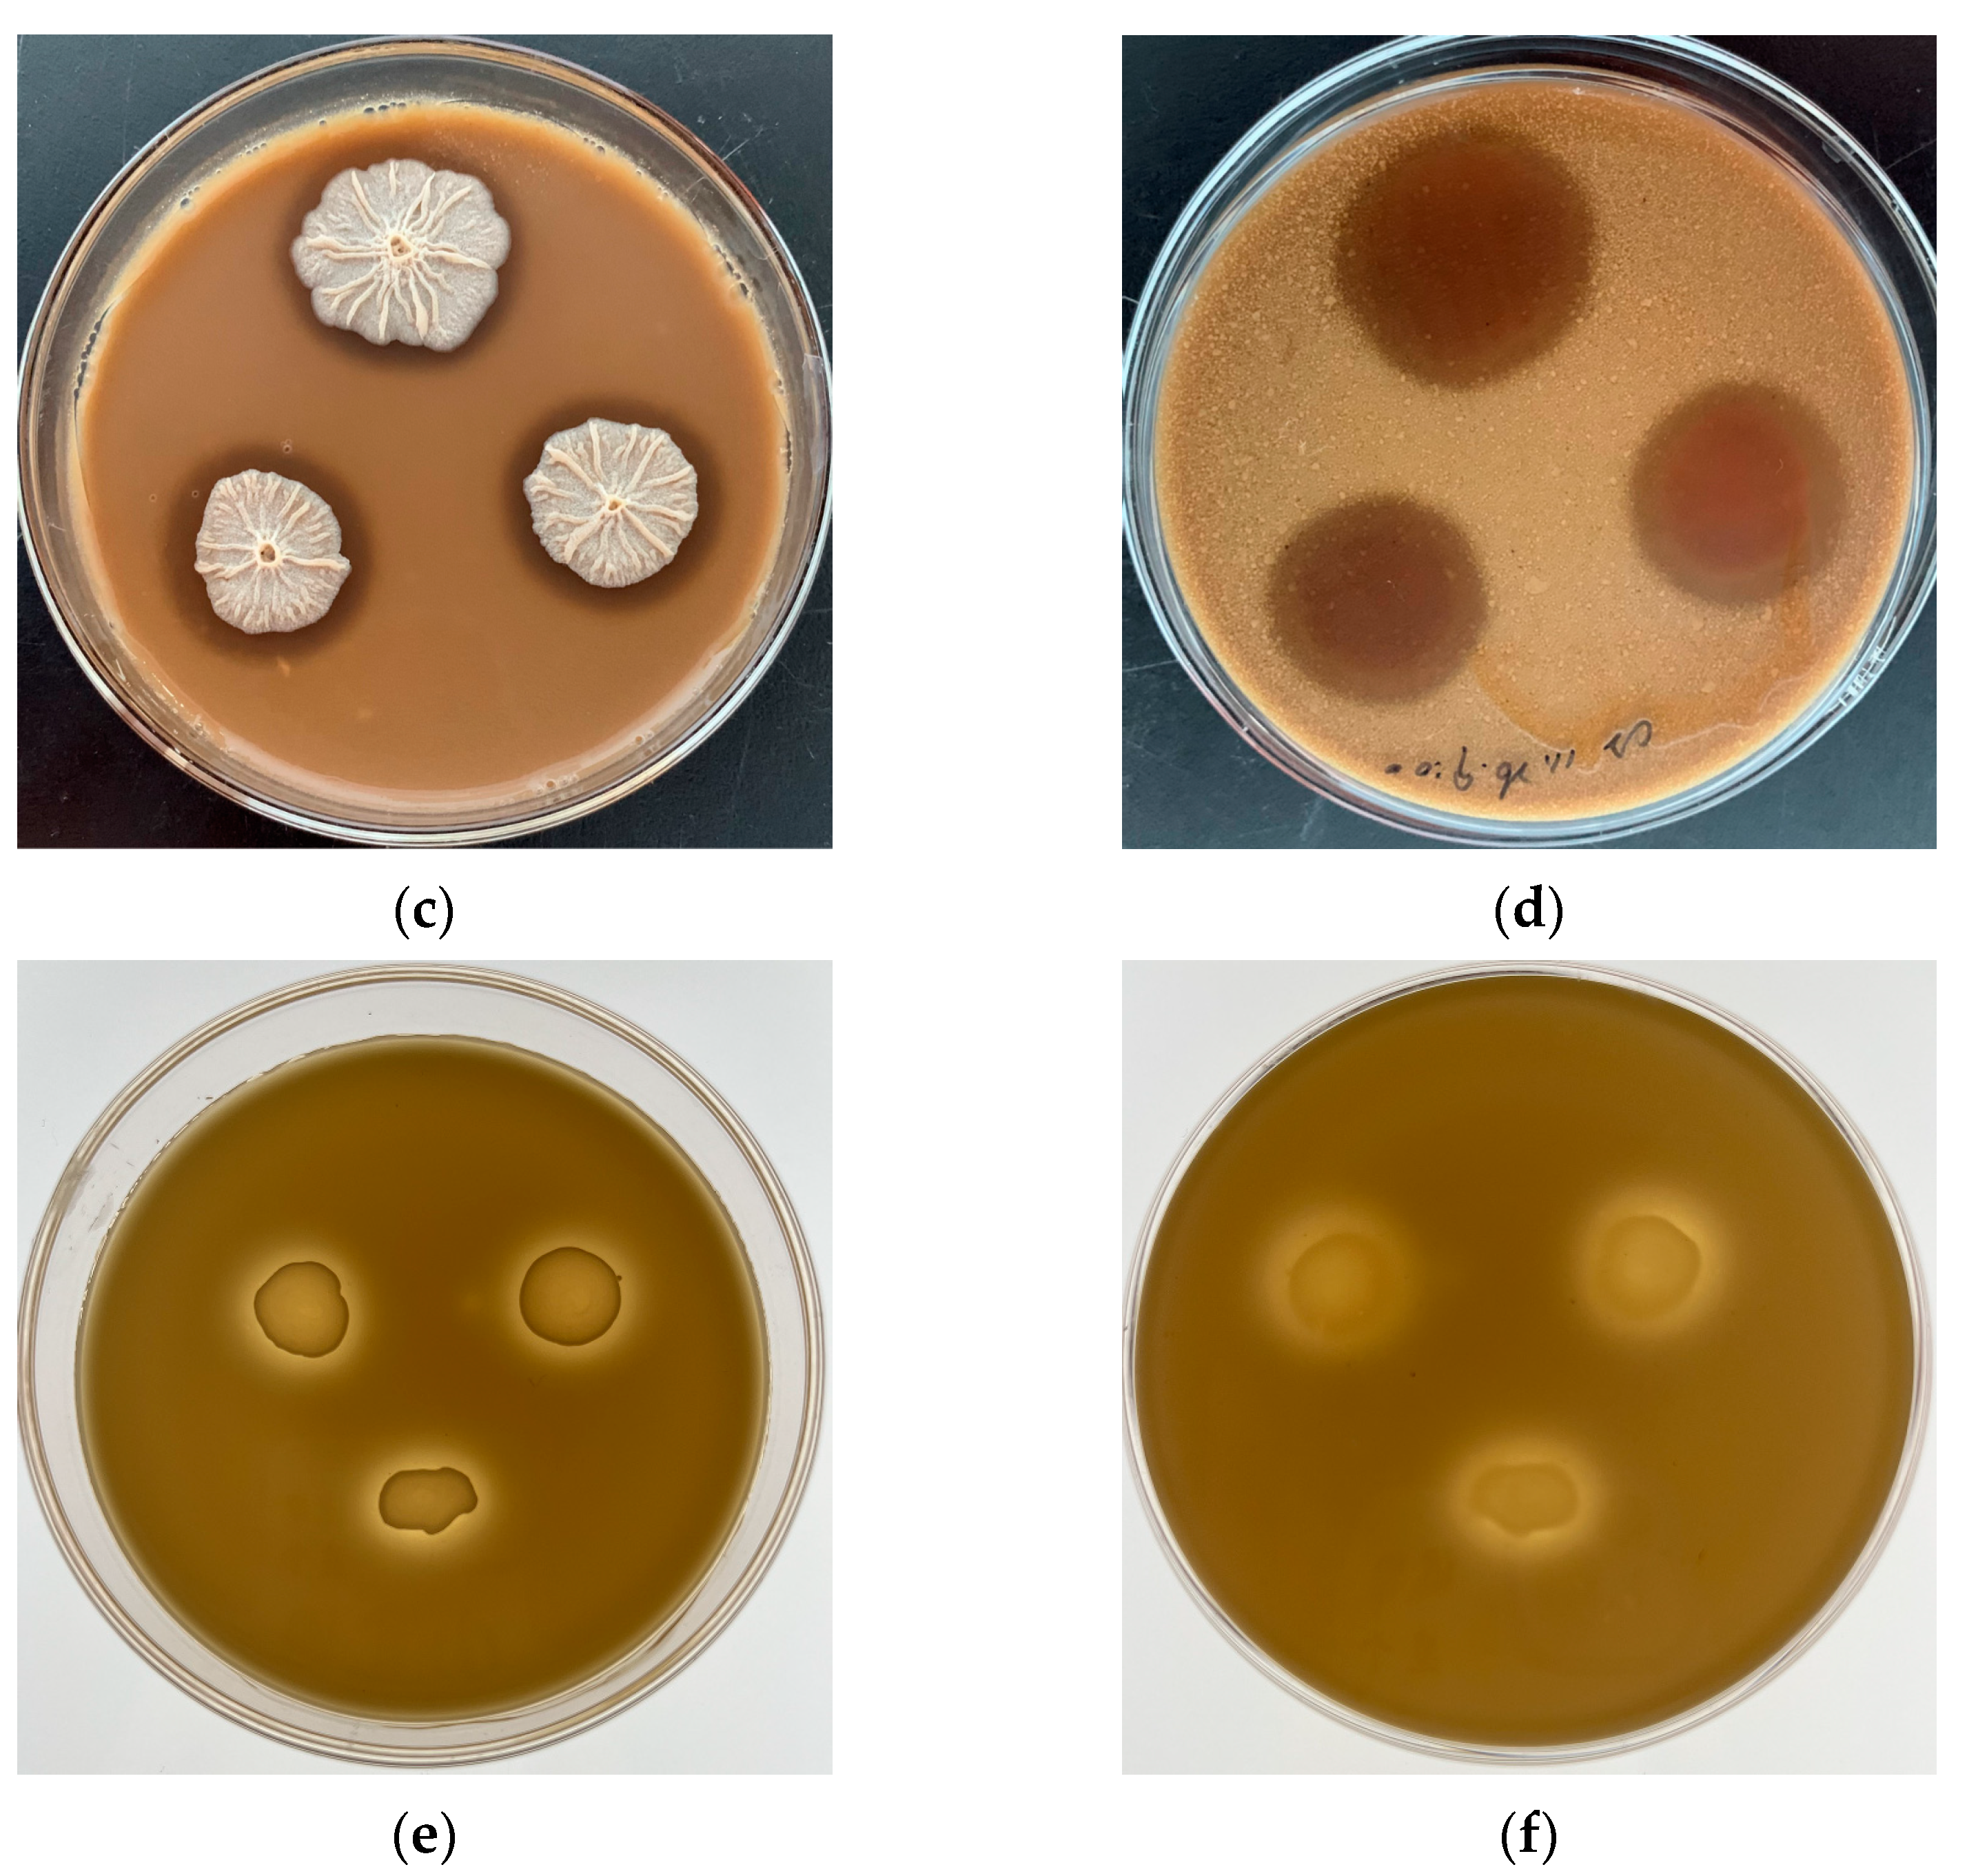
Foods 12 04336 g0a1b

Preparation of Glutamine-Enriched Fermented Feed from Corn Gluten Meal and Its Functionality Evaluation
Abstract
:1. Introduction
2. Materials and Methods
2.1. Materials
2.2. Glutamine-Enriched CGM Fermented Feed Preparation
2.3. Nutritional Value Evaluation of the Glutamine-Enriched CGM Fermented Feed
2.4. Glutamine Content Evaluation
2.5. Animal, Design, and Diets
2.6. Sample Collection
2.7. Intestinal Morphometry Analysis
2.8. Determination of Serum and Jejunum Tissues’ Immunological Parameters
2.9. S rRNA High Throughput Sequencing
2.10. Statistical Analysis
3. Results
3.1. Chemical Compositions of the GCFF
3.2. Glutamine Content of the GCFF
3.3. Effects of Dietary GCFF Replacing SBM Supplementation on the Growth Performance of Broilers
3.4. Effects of Dietary GCFF Replacing SBM Supplementation on the Intestinal Morphometry of Broilers
3.5. Effects of Dietary GCFF Replacing SBM Supplementation on the Serum, Jejunum, and Ileum Tissues’ Immunoglobulins of Broilers
3.6. Effects of Dietary GCFF Replacing SBM Supplementation on the Intestinal Microbiota of Broilers
4. Discussion
5. Conclusions
Author Contributions
Funding
Institutional Review Board Statement
Data Availability Statement
Conflicts of Interest
Abbreviations
| ADFI | Average daily feed intake |
| ADG | Average daily gain |
| BTI | Bis-1,1-trifluoroacetoxy-iodobenzene |
| CD | Crypt depth |
| CGM | Corn gluten meal |
| FCR | Feed conversion rate |
| GCFF | Glutamine-enriched corn gluten meal fermented feed |
| Gln | Glutamine |
| OTU | Operational taxonomic units |
| PCoA | Principal coordinate component analysis |
| SBM | Soybean meal |
| UFF | Corn gluten meal unfermented feed |
| VCR | Villus height to crypt depth |
| VH | Villus height |
Appendix A

| No. | Sequence | Position in Protein | Protein Name | Access No. |
|---|---|---|---|---|
| 1 | QPPRPQP | 88–94 | Glutein-2 | P04706 |
| 2 | LRQQCCQQL | 151–159 | Glutein-2 | P04706 |
| 3 | LQQQPQSGQVA | 180–190 | Glutein-2 | P04706 |
| 4 | AAQIAQQL | 194–201 | Glutein-2 | P04706 |
| 5 | LQQP | 207–210 | Glutein-2 | P04706 |
| 6 | LRQQCCQQQM | 83–92 | Zein-beta | P06673 |
| 7 | AQQLQMMMQL | 101–110 | Zein-beta | P06673 |
| 8 | ALMQQQQQLL | 124–133 | Zein-beta | P06673 |
| 9 | LQQA | 58–61 | Zein-alpha A20 | P04703 |
| 10 | LFQQS | 73–77 | Zein-alpha A20 | P04703 |
| 11 | AQQLQQL | 92–98 | Zein-alpha A20 | P04703 |
| 12 | QQQQFL | 116–121 | Zein-alpha A20 | P04703 |
| 13 | LQQQL | 135–139 | Zein-alpha A20 | P04703 |
| 14 | QQQQLL | 151–156 | Zein-alpha A20 | P04703 |
| 15 | LQQQIL | 170–175 | Zein-alpha A20 | P04703 |
| 16 | LQLQQL | 210–215 | Zein-alpha A20 | P04703 |
References
- Wang, Y.; Liu, X.L.; Jin, L.; Wen, Q.N.; Zhang, Y.G.; Narasimha, K.; Yan, E.Y.; Wang, C.P.; Zheng, Y.B. Effects of Fermented Corn Gluten Meal on Growth Performance, Serum Parameters, Intestinal Morphology, and Immunity Performance of Three-Yellow Broilers. Can. J. Anim. Sci. 2019, 99, 408–417. [Google Scholar] [CrossRef]
- Olukomaiya, O.; Fernando, C.; Mereddy, R.; Li, X.H.; Sultanbawa, Y. Solid-State Fermented Plant Protein Sources in the Diets of Broiler Chickens: A Review. Anim. Nutr. 2019, 5, 319–330. [Google Scholar] [CrossRef] [PubMed]
- Wang, Y.; Sun, H.; Liu, X. A Novel Fermented Rapeseed Meal, Inoculated with Selected Protease-Assisting Screened B. Subtilis Y-4 and L. plantarum 6026, Showed High Availability and Strong Antioxidant and Immunomodulation Potential Capacity. Foods 2022, 11, 2118. [Google Scholar] [CrossRef] [PubMed]
- Lu, Y.; Wang, J.; Soladoye, O.P.; Aluko, R.E.; Fu, Y.; Zhang, Y. Preparation, Receptors, Bioactivity and Bioavailability of γ-Glutamyl Peptides: A Comprehensive Review. Trends Food Sci. Technol. 2021, 113, 301–314. [Google Scholar] [CrossRef]
- Satoh, J.; Tsujikawa, T.; Fujiyama, Y.; Bamba, T. Nutritional Benefits of Enteral Alanyl-Glutamine Supplementation on Rat Small Intestinal Damage Induced by Cyclophosphamide. J. Gastroenterol. Hepatol. 2003, 18, 719–725. [Google Scholar] [CrossRef] [PubMed]
- Tan, B.; Liu, H.L.; He, G.Z.; Xiao, H.; Xiao, D.F.; Liu, Y.H.; Wu, J.P.; Fang, J.; Yin, Y.L. Alanyl-Glutamine but Not Glycyl-Glutamine Improved the Proliferation of Enterocytes as Glutamine Substitution in Vitro. Amino Acids 2017, 49, 2023–2031. [Google Scholar] [CrossRef]
- Zou, T.D.; Deng, C.X.; Wang, Z.R.; Ye, Y.L.; You, J.M. Dietary Alanyl-Glutamine Improves Growth Performance of Weaned Piglets through Maintaining Intestinal Morphology and Digestion-Absorption Function. Animal 2019, 13, 1826–1833. [Google Scholar] [CrossRef]
- Tian, J.; He, G.; Mai, K.S.; Liu, C.D.; Zhou, H.H.; Wen, H. Dietary Ala-Gln Ameliorated Growth Suppression and Intestinal Injury Induced by Soya Saponin in Zebrafish. Aquaculture 2020, 529, 735748. [Google Scholar] [CrossRef]
- Xu, Q.B.; Hu, M.Y.; Li, M.; Hou, J.X.; Zhang, X.H.; Gao, Y.; Chachar, B.; Li, X. Dietary Bioactive Peptide Alanyl-Glutamine Attenuates Dextran Sodium Sulfate-Induced Colitis by Modulating Gut Microbiota. Oxidative Med. Cell. Longev. 2021, 2021, 5543003. [Google Scholar] [CrossRef]
- Zheng, X.Q.; Wang, J.T.; Liu, X.L.; Sun, Y.; Zheng, Y.J.; Wang, X.J.; Liu, Y. Effect of Hydrolysis Time on the Physicochemical and Functional Properties of Corn Glutelin by Protamex Hydrolysis. Food Chem. 2015, 172, 407–415. [Google Scholar] [CrossRef]
- Jing, Y.; Liu, X.L.; Wang, J.Y.; Ma, Y.Q.; Zheng, X.Q. Production of Corn Protein Hydrolysate with Glutamine-Rich Peptides and Its Antagonistic Function in Ulcerative Colitis in Vivo. Foods 2022, 11, 3359. [Google Scholar] [CrossRef] [PubMed]
- Wang, X.J.; Zheng, X.Q.; Kopparapu, N.K.; Cong, W.S.; Deng, Y.P.; Sun, X.J.; Liu, X.L. Purification and Evaluation of a Novel Antioxidant Peptide from Corn Protein Hydrolysate. Process Biochem. 2014, 49, 1562–1569. [Google Scholar] [CrossRef]
- Su, W.F.; Jiang, Z.P.; Wang, C.; Xu, B.C.; Lu, Z.Q.; Wang, F.Q.; Zong, X.; Jin, M.L.; Wang, Y.Z. Dynamics of Defatted Rice Bran in Physicochemical Characteristics, Microbiota and Metabolic Functions During Two-Stage Co-Fermentation. Int. J. Food Microbiol. 2022, 362, 109489. [Google Scholar] [CrossRef] [PubMed]
- Razzaq, A.; Shamsi, S.; Ali, A.; Ali, Q.; Sajjad, M.; Malik, A.; Ashraf, M. Microbial Proteases Applications. Front. Bioeng. Biotechnol. 2019, 7, 110. [Google Scholar] [CrossRef] [PubMed]
- Corsetti, A.; Settanni, L. Lactobacilli in Sourdough Fermentation. Food Res. Int. 2007, 40, 539–558. [Google Scholar] [CrossRef]
- Li, W.; Cheng, P.; Zhang, J.B.; Zhao, L.M.; Ma, Y.B.; Ding, K. Synergism of Microorganisms and Enzymes in Solid-State Fermentation of Animal Feed. A Review. J. Anim. Feed Sci. 2021, 30, 3–10. [Google Scholar] [CrossRef]
- AOAC. Official Methods of Analysis, 15th ed.; Association of Official Analytical Chemists: Arlington, VA, USA, 1990. [Google Scholar]
- GB/T 6434-2022; Feeding stuffs-Determination of Crude Fiber Content. Standards Press of China: Beijing, China, 2022.
- NY/T 1459-2022; Determination of Acid Detergent Fiber (ADF) in Feeds. Standards Press of China: Beijing, China, 2022.
- GB/T 20806-2022; Determination of Neutral Detergent Fiber (NDF) in Feeds. Standards Press of China: Beijing, China, 2022.
- GB/T 10468-1989; Fruit and Vegetable Products-Determination of pH. Standards Press of China: Beijing, China, 1989.
- Wang, Y.C.; Xu, K.K.; Lu, F.; Wang, Y.N.; Ouyang, N.N.; Ma, H.L. Increasing Peptide Yield of Soybean Meal Solid-State Fermentation of Ultrasound-Treated Bacillus amyloliquefaciens. Innov. Food Sci. Emerg. Technol. 2021, 72, 102704. [Google Scholar] [CrossRef]
- Zheng, X.Q.; Li, L.T.; Liu, X.L.; Wang, X.J.; Lin, J.; Li, D. Production of Hydrolysate with Antioxidative Activity by Enzymatic Hydrolysis of Extruded Corn Gluten. Appl. Microbiol. Biotechnol. 2006, 73, 763–770. [Google Scholar] [CrossRef]
- Miyaji, T.; Otta, Y.; Nakagawa, T.; Watanabe, T.; Niimura, Y.; Tomizuka, N. Purification and Molecular Characterization of Subtilisin-Like Alkaline Protease BPP-A from Bacillus pumilus Strain MS-1. Lett. Appl. Microbiol. 2006, 42, 242–247. [Google Scholar] [CrossRef]
- Jiang, X.; Liu, X.; Xu, H.J.; Sun, Y.K.; Zhang, Y.G.; Wang, Y. Improvement of the Nutritional, Antioxidant and Bioavailability Properties of Corn Gluten-Wheat Bran Mixture Fermented with Lactic Acid Bacteria and Acid Protease. LWT-Food Sci. Technol. 2021, 144, 111–116. [Google Scholar] [CrossRef]
- Kocabiyik, S.; Ozel, H. An Extracellular—Pepstatin Insensitive Acid Protease Produced by Thermoplasma volcanium. Bioresour. Technol. 2007, 98, 112–117. [Google Scholar] [CrossRef] [PubMed]
- Zhou, Y.X.; Zhang, P.S.; Deng, G.C.; Liu, X.M.; Lu, D.X. Improvements of Immune Status, Intestinal Integrity and Gain Performance in the Early-Weaned Calves Parenterally Supplemented with L-Alanyl-L-Glutamine Dipeptide. Vet. Immunol. Immunopathol. 2012, 145, 134–142. [Google Scholar] [CrossRef] [PubMed]
- Abdulkarimi, R.; Shahir, M.H.; Daneshyar, M. Effects of Dietary Glutamine and Arginine Supplementation on Performance, Intestinal Morphology and Ascites Mortality in Broiler Chickens Reared under Cold Environment. Asian-Australas. J. Anim. Sci. 2019, 32, 110–117. [Google Scholar] [CrossRef] [PubMed]
- Carvalho, P.L.P.F.; Xavier, W.d.S.; Guimarães, M.G.; Rodrigues, E.J.D.; Furuya, W.M.; Yamamoto, F.Y.; Pezzato, L.E.; Gatlin, D.M.; Barros, M.M. Dietary Glutamine Improves Growth and Intestinal Morphology of Juvenile Gift Tilapia (Oreochromis niloticus) but Has Limited Effects on Innate Immunity and Antioxidant Capacity. Aquaculture 2023, 563, 738976. [Google Scholar] [CrossRef]
- Roth, E. Nonnutritive Effects of Glutamine. J. Nutr. 2008, 138, 2025s–2031s. [Google Scholar] [CrossRef] [PubMed]
- Mowat, A.M.; Agace, W.W. Regional Specializations within the Intestinal Immune System. Nat. Rev. Immunol. 2014, 14, 667–685. [Google Scholar] [CrossRef]
- Tian, J.; Hao, L.; Chandra, P.; Jones, D.P.; Willams, I.R.; Gewirtz, A.T.; Ziegler, T.R. Dietary Glutamine and Oral Antibiotics Each Improve Indexes of Gut Barrier Function in Rat Short Bowel Syndrome. Am. J. Physiol.-Gastrointest. Liver Physiol. 2009, 296, G348–G355. [Google Scholar] [CrossRef]
- Zhang, Y.; Zhao, L.; Zhou, Y.; Diao, C.; Han, L.; Yinjie, N.; Liu, S.; Chen, H. Glutamine Ameliorates Mucosal Damage Caused by Immune Responses to Duck Plague Virus. Dose-Response 2017, 15, 1559325817708674. [Google Scholar] [CrossRef]
- Liu, J.; Zong, C.G.; Yu, X.; Ding, Y.; Chang, B.; Wang, R.Y.; Sang, L.X. Alanyl-Glutamine (Ala-Gln) Ameliorates Dextran Sulfate Sodium (DSS)-Induced Acute Colitis by Regulating the Gut Microbiota, Pi3k-Akt/NF-κB/STAT3 Signaling, and Associated Pulmonary Injury. ACS Infect. Dis. 2023, 9, 979–992. [Google Scholar] [CrossRef]
- Yan, Y.Q.; Xu, B.Y.; Yin, B.Q.; Xu, X.F.; Niu, Y.R.; Tang, Y.M.; Wang, X.K.; Xie, C.L.; Yang, T.; Zhou, S.Y.; et al. Modulation of Gut Microbial Community and Metabolism by Dietary Glycyl-Glutamine Supplementation May Favor Weaning Transition in Piglets. Front. Microbiol. 2020, 10, 3125. [Google Scholar] [CrossRef]
- Forchhammer, K. Glutamine Signalling in Bacteria. Front. Biosci.-Landmark 2007, 12, 358–370. [Google Scholar] [CrossRef]
- Dai, Z.L.; Li, X.L.; Xi, P.B.; Zhang, J.; Wu, G.Y.; Zhu, W.Y. L-Glutamine Regulates Amino Acid Utilization by Intestinal Bacteria. Amino Acids 2013, 45, 501–512. [Google Scholar] [CrossRef]
- Koo, B.; Kim, J.W.; Nyachoti, C.M. Nutrient and Energy Digestibility, and Microbial Metabolites in Weaned Pigs Fed Diets Containing Lactobacillus–Fermented Wheat. Anim. Feed Sci. Technol. 2018, 241, 27–37. [Google Scholar] [CrossRef]
- Canon, F.; Nidelet, T.; Guedon, E.; Thierry, A.; Gagnaire, V. Understanding the Mechanisms of Positive Microbial Interactions That Benefit Lactic Acid Bacteria Co-Cultures. Front. Microbiol. 2020, 11, 2088. [Google Scholar] [CrossRef] [PubMed]
- Lin, W.C.; Lee, T.T. Effects of Laetiporus sulphureus-Fermented Wheat Bran on Growth Performance, Intestinal Microbiota and Digesta Characteristics in Broiler Chickens. Animals 2020, 10, 1457. [Google Scholar] [CrossRef] [PubMed]
- Garg, S.; Singh, T.P.; Reddi, S.; Malik, R.K.; Kapila, S. Intervention of Probiotic L-reuteri Fermented Milk as an Adjuvant to Combat Protein Energy Malnourishment Induced Gut Disturbances in Albino Mice. J. Funct. Foods 2017, 36, 467–479. [Google Scholar] [CrossRef]
- Macfarlane, G.T.; Cummings, J.H.; Allison, C. Protein-Degradation by Human Intestinal Bacteria. J. Gen. Microbiol. 1986, 132, 1647–1656. [Google Scholar] [CrossRef]
- Korpela, K. Diet, Microbiota, and Metabolic Health: Trade-Off between Saccharolytic and Proteolytic Fermentation. Annu. Rev. Food Sci. Technol. 2018, 9, 65–84. [Google Scholar] [CrossRef]
- Konstantinov, S.R.; Awati, A.A.; Williams, B.A.; Miller, B.G.; Jones, P.; Stokes, C.R.; Akkermans, A.D.L.; Smidt, H.; De Vos, W.M. Post-Natal Development of the Porcine Microbiota Composition and Activities. Environ. Microbiol. 2006, 8, 1191–1199. [Google Scholar] [CrossRef]
- Dai, Z.L.; Wu, G.Y.; Zhu, W.Y. Amino Acid Metabolism in Intestinal Bacteria: Links between Gut Ecology and Host Health. Front. Biosci.-Landmark 2011, 16, 1768–1786. [Google Scholar] [CrossRef]




| Item | 1–21 Days | 22–42 Days | ||||||
|---|---|---|---|---|---|---|---|---|
| CON | GCFF15 | GCFF30 | GCFF60 | CON | GCFF15 | GCFF30 | GCFF60 | |
| Ingredients (%, as-fed basis) | ||||||||
| Corn | 57.49 | 59.77 | 57.47 | 57.97 | 62.00 | 63.40 | 62.00 | 62.40 |
| Soybean meal | 35.80 | 29.63 | 25.06 | 14.32 | 31.07 | 26.41 | 21.75 | 12.43 |
| CGM fermented feed | 0.00 | 5.37 | 10.74 | 21.48 | 0.00 | 4.66 | 9.32 | 18.65 |
| Soybean oil | 3.00 | 2.52 | 3.00 | 2.32 | 3.60 | 2.20 | 3.60 | 3.00 |
| Limestone | 1.27 | 1.27 | 1.27 | 1.27 | 1.21 | 1.21 | 1.21 | 1.21 |
| Dicalcium phosphate | 1.45 | 1.45 | 1.45 | 1.45 | 1.20 | 1.20 | 1.20 | 1.20 |
| Choline chloride | 0.20 | 0.20 | 0.20 | 0.20 | 0.20 | 0.20 | 0.20 | 0.20 |
| NaCl | 0.35 | 0.35 | 0.35 | 0.35 | 0.37 | 0.37 | 0.37 | 0.37 |
| Premix 1 | 0.22 | 0.22 | 0.22 | 0.22 | 0.22 | 0.22 | 0.22 | 0.22 |
| DL-Methionine (98%) | 0.20 | 0.20 | 0.20 | 0.20 | 0.12 | 0.12 | 0.12 | 0.12 |
| L-Lysine-HCl (99%) | 0.02 | 0.02 | 0.04 | 0.20 | 0.01 | 0.01 | 0.01 | 0.20 |
| Nutrient levels (Calculate values) | ||||||||
| Metabolizable energy (MJ/kg) | 12.37 | 12.38 | 12.54 | 12.53 | 12.72 | 12.70 | 12.86 | 12.85 |
| Crude protein (%) | 20.42 | 20.17 | 20.42 | 20.46 | 18.69 | 18.72 | 18.69 | 18.73 |
| Crude fat (%) | 5.69 | 5.34 | 5.87 | 5.40 | 6.35 | 6.05 | 6.50 | 6.08 |
| Crude fiber (%) | 3.43 | 3.33 | 3.26 | 3.10 | 3.26 | 3.19 | 3.11 | 2.96 |
| Total phosphorus (%) | 0.80 | 0.80 | 0.79 | 0.79 | 0.71 | 0.71 | 0.70 | 0.70 |
| Calcium (%) | 1.90 | 1.91 | 1.87 | 1.86 | 1.89 | 1.89 | 1.87 | 1.85 |
| Lysin (%) | 1.12 | 1.01 | 0.96 | 0.96 | 0.99 | 0.91 | 0.83 | 0.87 |
| Methionine (%) | 0.50 | 0.51 | 0.53 | 0.55 | 0.41 | 0.42 | 0.43 | 0.45 |
| Item | UFF | GCFF |
|---|---|---|
| Dry matter (%) | 90.52 ± 0.19 | 90.13 ± 0.28 |
| Crude protein (%) | 40.46 ± 0.28 | 41.33 ± 0.46 |
| Crude fiber (%) | 12.98 ± 0.09 a | 9.10 ± 0.04 b |
| Crude fat (%) | 2.50 ± 0.11 a | 2.17 ± 0.04 b |
| Acid detergent fiber (%) | 28.36 ± 0.18 a | 23.53 ± 0.25 b |
| Neutral detergent fiber (%) | 8.43 ± 0.12 | 8.22 ± 0.09 |
| pH | 5.2 a | 4.6 b |
| Glutamine content (mg/g soluble protein) | 1.60 ± 0.16 b | 12.80 ± 0.14 a |
| Small peptide content (mg/g) | 76.10 ± 0.96 b | 112.30 ± 1.05 a |
| Soluble protein content (mg/g) | 82.40 ± 0.82 b | 140.70 ± 1.98 a |
| Lactic acid content (mg/g) | 13.18 ± 0.03 b | 29.78 ± 0.19 a |
| Lactobacillus (CFU/g) | Undetected | 2.6 × 106 |
| Bacillus subtilis (CFU/g) | Undetected | 1.1 × 105 |
| Item | Time | CON | GCFF15 | GCFF30 | GCFF60 | SEM | p-Value |
|---|---|---|---|---|---|---|---|
| ADG (g) | 1–21 days | 34.0 c | 37.4 a | 35.8 b | 33.4 c | 0.919 | <0.001 |
| 22–42 days | 82.9 c | 92.0 a | 88.3 b | 76.0 d | 3.491 | <0.001 | |
| 1–42 days | 60.7 c | 66.3 a | 62.2 b | 54.6 d | 2.413 | <0.001 | |
| ADFI (g) | 1–21 days | 53.3 | 54.5 | 54.9 | 52.3 | 0.599 | 0.063 |
| 22–42 days | 172.7 a | 173.2 a | 173.5 a | 160.2 b | 3.237 | <0.001 | |
| 1–42 days | 113.0 a | 113.8 a | 114.2 a | 106.2 b | 1.877 | <0.001 | |
| FCR | 1–21 days | 1.56 | 1.52 | 1.52 | 1.60 | 0.019 | 0.156 |
| 22–42 days | 1.98 b | 1.82 c | 1.98 b | 2.08 a | 0.054 | <0.001 | |
| 1–42 days | 1.86 b | 1.74 c | 1.84 b | 1.94 a | 0.042 | <0.001 |
| Item | CON | GCFF15 | GCFF30 | GCFF60 | SEM | p-Value |
|---|---|---|---|---|---|---|
| Serum | ||||||
| IgM (μg/mL) | 624.9 | 632.2 | 624.9 | 605.1 | 5.039 | 0.414 |
| IgG (μg/mL) | 1793.9 b | 2135.9 a | 2039.5 a | 2056.6 a | 63.997 | 0.006 |
| IgA (μg/mL) | 215.0 | 232.9 | 207.4 | 205.8 | 5.376 | 0.096 |
| Jejunum tissues | ||||||
| IgM (μg/mL) | 548.6 b | 603.8 a | 605.9 a | 566.2 b | 12.269 | <0.001 |
| IgG (μg/mL) | 1609.9 b | 1793.5 a | 1850.6 a | 1798.3 a | 45.617 | <0.001 |
| IgA (μg/mL) | 210.4 b | 238.0 a | 226.9 a | 220.9 ab | 4.994 | 0.005 |
| Ileum tissues | ||||||
| IgM (μg/mL) | 580.4 b | 636.0 a | 628.9 a | 580.8 b | 15.038 | 0.003 |
| IgG (μg/mL) | 1383.7 b | 1635.4 a | 1723.2 a | 1629.0 a | 72.948 | 0.001 |
| IgA (μg/mL) | 224.1 | 230.1 | 238.1 | 213.7 | 5.140 | 0.108 |
Disclaimer/Publisher’s Note: The statements, opinions and data contained in all publications are solely those of the individual author(s) and contributor(s) and not of MDPI and/or the editor(s). MDPI and/or the editor(s) disclaim responsibility for any injury to people or property resulting from any ideas, methods, instructions or products referred to in the content. |
© 2023 by the authors. Licensee MDPI, Basel, Switzerland. This article is an open access article distributed under the terms and conditions of the Creative Commons Attribution (CC BY) license (https://creativecommons.org/licenses/by/4.0/).
Share and Cite
Fan, L.; Liu, X.; Deng, Y.; Zheng, X. Preparation of Glutamine-Enriched Fermented Feed from Corn Gluten Meal and Its Functionality Evaluation. Foods 2023, 12, 4336. https://doi.org/10.3390/foods12234336
Fan L, Liu X, Deng Y, Zheng X. Preparation of Glutamine-Enriched Fermented Feed from Corn Gluten Meal and Its Functionality Evaluation. Foods. 2023; 12(23):4336. https://doi.org/10.3390/foods12234336
Chicago/Turabian StyleFan, Lei, Xiaolan Liu, Yongping Deng, and Xiqun Zheng. 2023. "Preparation of Glutamine-Enriched Fermented Feed from Corn Gluten Meal and Its Functionality Evaluation" Foods 12, no. 23: 4336. https://doi.org/10.3390/foods12234336
APA StyleFan, L., Liu, X., Deng, Y., & Zheng, X. (2023). Preparation of Glutamine-Enriched Fermented Feed from Corn Gluten Meal and Its Functionality Evaluation. Foods, 12(23), 4336. https://doi.org/10.3390/foods12234336
